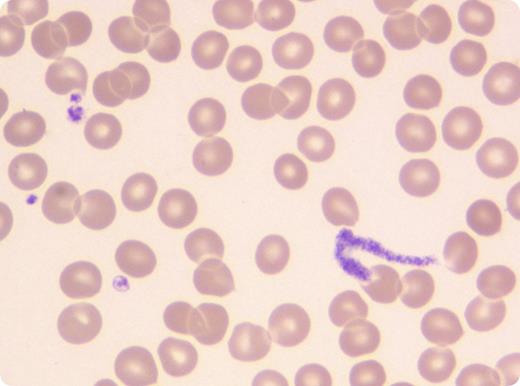

An 82-year-old woman was admitted to our institution with profound thrombocytopenia (1 × 109/L) without bleeding symptoms. The diagnosis of immune thrombocytopenic purpura had been made 18 months earlier, and the patient had presented recurrent thrombocytopenic relapses since then. A treatment with intravenous gamma globulin was initiated for the current episode. Two days later, her platelet count had increased to 60 × 109/L. On this occasion, her blood smear showed the unusual image of a proplatelet, appearing as a thin, elongated, and seamless cytoplasmic strand with the same tinctorial affinity as platelets. No platelet clumps were found on the smear.
The mechanisms of platelet production are still incompletely understood. Either megakaryocytes extend long cytoplasmic structures called proplatelets through the vascular wall of bone marrow sinusoids, or megakaryocytes are wholly released in the circulation and develop proplatelets under the circulatory shear stress. Both models suggest that proplatelets are present in the bloodstream where they further fragment into platelets. However, if proplatelets are usual observations in megakaryocyte cultures, they are very rarely seen in the peripheral blood. This image, observed in a situation where platelet production is stimulated, supports the relevance of these 2 models of in vivo platelet production in human physiology.
An 82-year-old woman was admitted to our institution with profound thrombocytopenia (1 × 109/L) without bleeding symptoms. The diagnosis of immune thrombocytopenic purpura had been made 18 months earlier, and the patient had presented recurrent thrombocytopenic relapses since then. A treatment with intravenous gamma globulin was initiated for the current episode. Two days later, her platelet count had increased to 60 × 109/L. On this occasion, her blood smear showed the unusual image of a proplatelet, appearing as a thin, elongated, and seamless cytoplasmic strand with the same tinctorial affinity as platelets. No platelet clumps were found on the smear.
The mechanisms of platelet production are still incompletely understood. Either megakaryocytes extend long cytoplasmic structures called proplatelets through the vascular wall of bone marrow sinusoids, or megakaryocytes are wholly released in the circulation and develop proplatelets under the circulatory shear stress. Both models suggest that proplatelets are present in the bloodstream where they further fragment into platelets. However, if proplatelets are usual observations in megakaryocyte cultures, they are very rarely seen in the peripheral blood. This image, observed in a situation where platelet production is stimulated, supports the relevance of these 2 models of in vivo platelet production in human physiology.
For additional images, visit the ASH IMAGE BANK, a reference and teaching tool that is continually updated with new atlas and case study images. For more information visit http://imagebank.hematology.org.